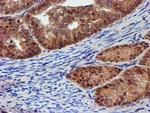
PSMD2 Antibody in Immunohistochemistry (Paraffin) (IHC (P))

Search
Invitrogen
PSMD2 Monoclonal Antibody (OTI1G6)
{{$productOrderCtrl.translations['antibody.pdp.commerceCard.promotion.promotions']}}
{{$productOrderCtrl.translations['antibody.pdp.commerceCard.promotion.viewpromo']}}
{{$productOrderCtrl.translations['antibody.pdp.commerceCard.promotion.promocode']}}: {{promo.promoCode}} {{promo.promoTitle}} {{promo.promoDescription}}. {{$productOrderCtrl.translations['antibody.pdp.commerceCard.promotion.learnmore']}}

Please note: We are reviewing Western blot images included in the antibody testing data in our catalog, including those provided by third parties. Unless expressly labeled or annotated as “raw-unedited”, Western blot images included in the antibody testing data in our catalog may have been edited, optimized or otherwise adjusted for presentation.
产品信息
MA5-25624
种属反应
宿主/亚型
分类
类型
克隆号
抗原
偶联物
形式
浓度
规格
纯化类型
保存液
内含物
保存条件
运输条件
RRID
靶标信息
The 26S proteasome is a multicatalytic proteinase complex with a highly ordered structure composed of 2 complexes, a 20S core and a 19S regulator. The 20S core is composed of 4 rings of 28 non-identical subunits; 2 rings are composed of 7 alpha subunits and 2 rings are composed of 7 beta subunits. The 19S regulator is composed of a base, which contains 6 ATPase subunits and 2 non-ATPase subunits, and a lid, which contains up to 10 non-ATPase subunits. Proteasomes are distributed throughout eukaryotic cells at a high concentration and cleave peptides in an ATP/ubiquitin-dependent process in a non-lysosomal pathway. An essential function of a modified proteasome, the immunoproteasome, is the processing of class I MHC peptides. This gene encodes one of the non-ATPase subunits of the 19S regulator lid. In addition to participation in proteasome function, this subunit may also participate in the TNF signalling pathway since it interacts with the tumor necrosis factor type 1 receptor. A pseudogene has been identified on chromosome 1.
仅用于科研。不用于诊断过程。未经明确授权不得转售。
篇参考文献 (0)
生物信息学
蛋白别名: 26S proteasome non-ATPase regulatory subunit 2; 26S proteasome regulatory subunit RPN1; 26S proteasome regulatory subunit S2; 26S proteasome subunit p97; F23F1.8; MGC14274; proteasome (prosome, macropain) 26S subunit, non-ATPase, 2; Protein 55.11; testis expressed gene 190; Tumor necrosis factor type 1 receptor-associated protein 2
基因别名: 9430095H01Rik; AA407121; PSMD2; TEG-190; Tex190; TRAP2
UniProt ID: (Rat) Q4FZT9, (Mouse) Q8VDM4
Entrez Gene ID: (Dog) 478654, (Rat) 287984, (Mouse) 21762




